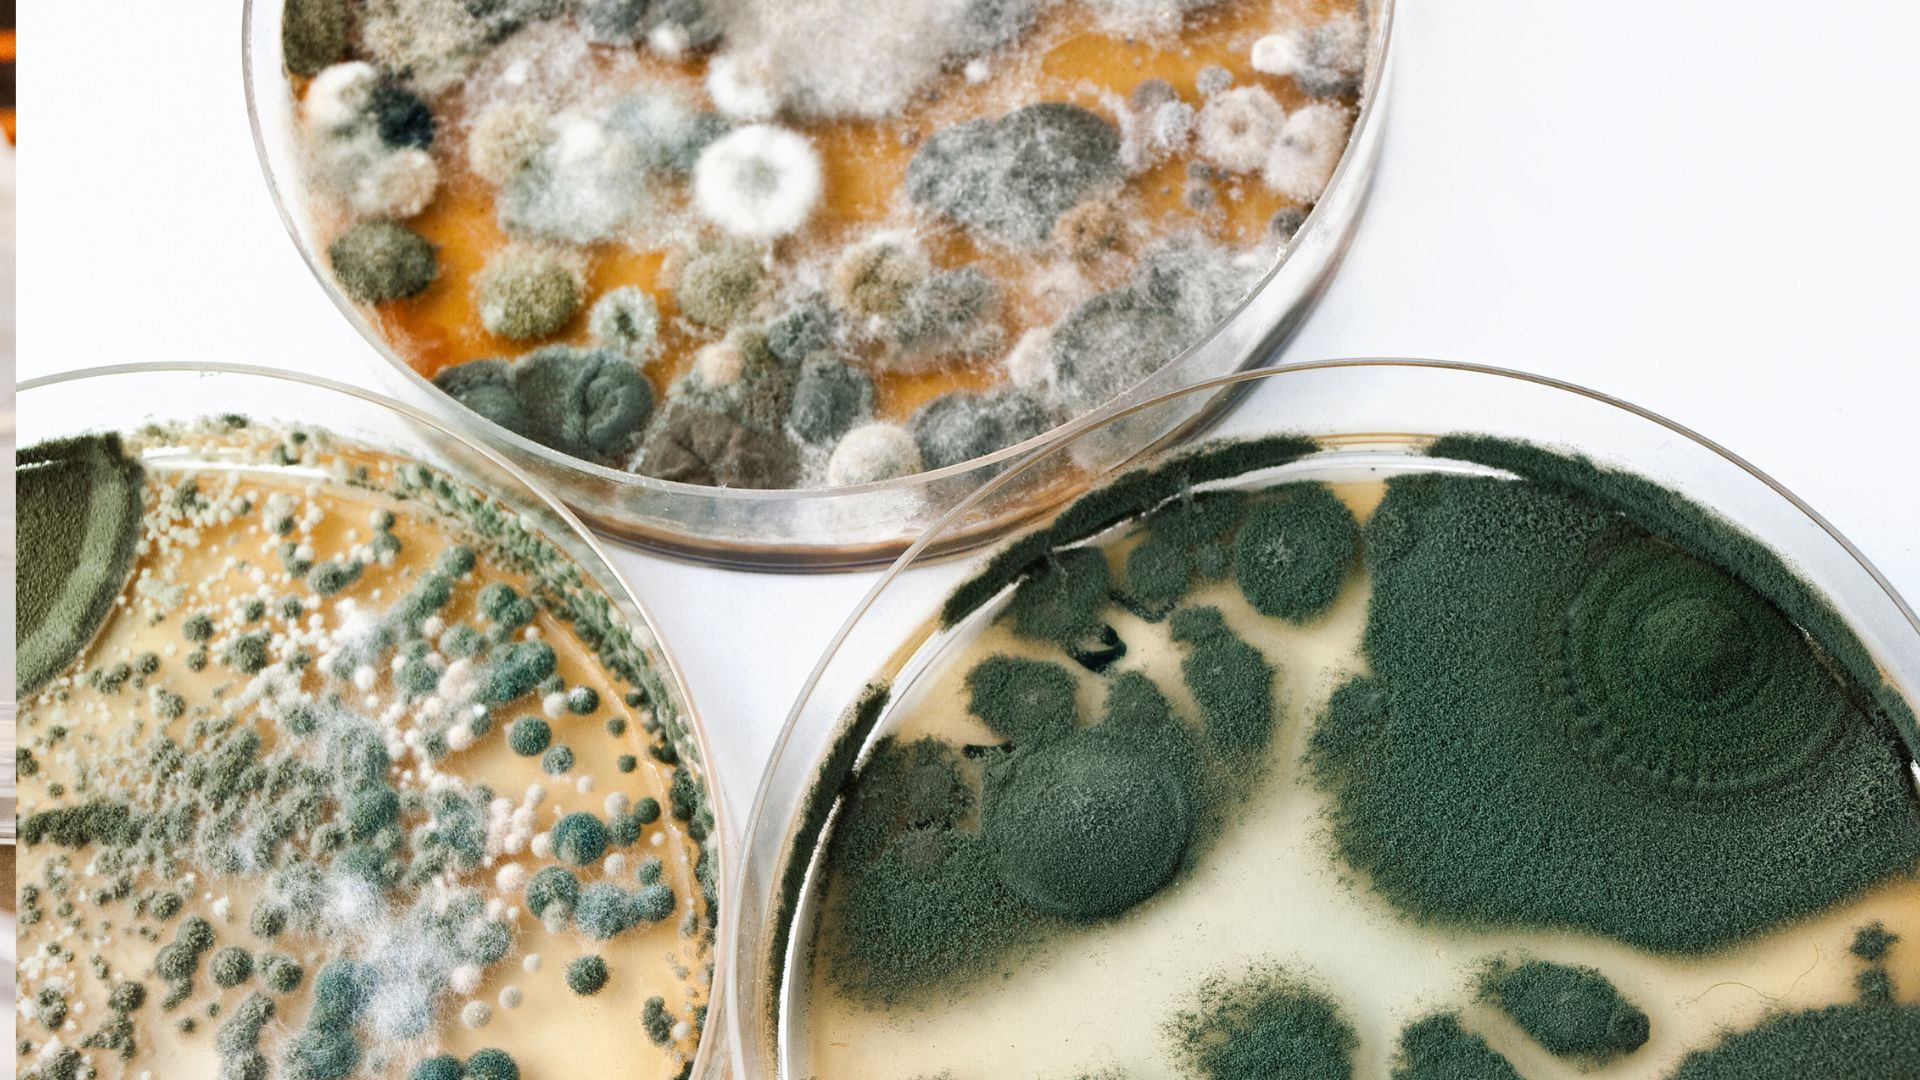
Aislamiento de un hongo: cómo depurar un cultivo y obtener una cepa pura

🍄 Selecciona tu región de envío
Productos premium para cultivo de hongos con envío adaptado a tu ubicación

🇨🇴 Envíos a Colombia
Vía 4-72 Casillero Virtual
1️⃣ Afíliate en casillerovirtual.com.co
2️⃣ Usa tu dirección en España
3️⃣ Recibe en Colombia en 4-7 días
⚠️ Atención: Los productos de micolegas.com se envían exclusivamente desde España peninsular. Para Argentina y Colombia, sigue las indicaciones de tu región.
🍄 Artículos Premium para Amantes de la Micología
Encuentra todo lo que necesitas para tu cultivo en nuestra tienda especializada

Liquid Cultures

Asesoría especializada

Invernaderos • Humedad • Temperatura

Sensores • Control remoto • IoT
🔬 ¿Por qué elegir Micolegas?
- Divulgavión y cooperación
- Programas de formación
- Asesoría personalizada
- Guías ilustradas disponibles en la web
- Sustratos listos para fructificar
- Micelios testeados en laboratorio
- Accede a una comunidad internacional de más de 100.000 personas que aman la micología
Tu Tienda de Micología Premium en España
Calidad, ciencia y pasión por los hongos
En Micolegas nos dedicamos a ofrecer a los amantes de la micología los mejores productos para el cultivo de hongos comestibles y medicinales. Nuestra misión es brindarte materiales de alta calidad, cepas verificadas y el conocimiento necesario para que tu experiencia de cultivo sea exitosa desde el primer intento.
🎯 Para principiantes
Kits todo-en-uno con guías paso a paso, micelios de alta vitalidad y soporte personalizado. Empieza tu aventura micológica con confianza.
🔬 Para expertos
Material de laboratorio profesional, prints de esporas para microscopía, placas Petri y equipamiento para técnicas avanzadas de cultivo.
Todos nuestros productos han sido cuidadosamente seleccionados para garantizar la mejor experiencia en el cultivo de micelios y esporas. Ya sea que busques cultivar ostras, shiitake, melena de león o especies medicinales, en Micolegas encontrarás el equipamiento y el conocimiento para lograrlo.
🍄 Únete a la Comunidad Fungícola
Recibe guías exclusivas, ofertas y novedades de cultivo directamente en tu email
✓ Sin spam • Cancela cuando quieras • +2.800 fungicultores suscritos

Guía práctica de gestión y reutilización del sustrato de cultivo de hongos (SMS): de residuo a recurso sostenible
Calcarisporium cordycipiticola, el parásito del Cordyceps
Chaga, la bomba de los abedules
Cepas albinas y leucistas, ¿es lo mismo?, NO
Guía completa sobre el cultivo de Trametes versicolor (cola de pavo)
Guía completa de Cultivo de Cordyceps militaris
Guía completa para cultivar la deliciosa seta de chopo
Cultivo y propiedades medicinales del hongo chaga (Inonotus obliquus)
Cultivo y propiedades de la Melena de León: Guía completa paso a paso
Historia de las setas desde el origen del ser humano: una mirada al pasado y al presente de estos fascinantes organismos